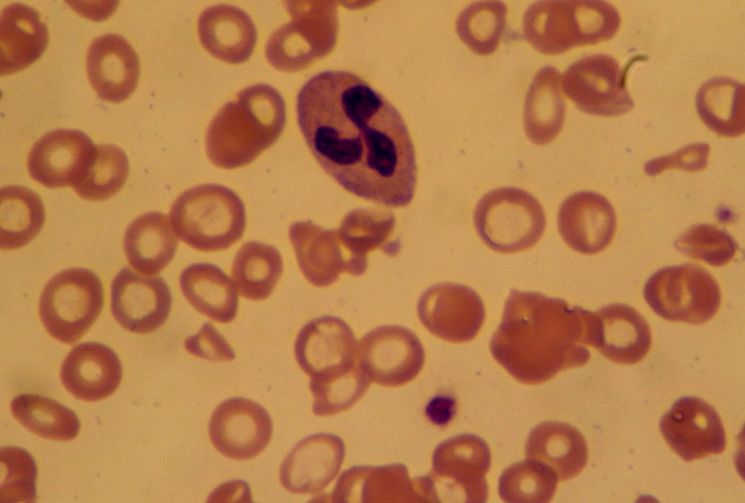

Железо является важным природным элементом, который необходим для здоровья человека, дефицит железа часто приводит к анемии. Железодефицитная анемия — это гематологический синдром, характеризующийся нарушением синтеза гемоглобина в крови человека вследствие дефицита железа и проявляющийся анемией и сидеропенией.
Недостаток железа в организме может быть связан с плохим питанием, с потерей большого количества крови, либо с кровотечением во время менструального цикла у женщин.
- Симптомы недостатка железа в организме
- Таблица продуктов, богатых железом
- Суточная потребность организма в железе
- Симптомы избытка железа
- Как улучшить усвоение железа для борьбы с анемией?
- Препараты для повышения гемоглобина и борьбы с анемией
- Длительность лечения анемии
- Виды железосодержащих препаратов

Симптомы недостатка железа в организме
В этом списке мы приводим симптомы недостатка железа в организме человека (железодефицитной анемии):
- повышенная утомляемость;
- опухшие лодыжки или отек в других суставах;
- выпадение и ломкость волос;
- бледная кожа;
- отсутствие аппетита;
- частые инфекции из-за низкого иммунитета;
Самым простым способом борьбы с железодефицитной анемией является потребление продуктов богатых железом. Основными продуктами с повышенным содержанием железом являются: красное мясо, птица, рыба, сердце, печень, креветки и крабы, тофу, орехи, семена льна, кунжута, капуста, кориандр, чернослив, фасоль, горох, чечевица, коричневый рис и др.
Тем не менее, в любом случае на самолечение серьезно рассчитывать не стоит! Обнаружив у себя вышеописанные симптомы важно сделать анализ крови, чтобы детектировать дефицит железа в организме. Если врач считает, что уровень железа в крови очень низкий, он может назначит диету, а также дополнительный прием лекарственных препаратов железа в течение определенного времени (иногда продолжительностью до нескольких месяцев).
Вы должны понимать, что продукты богатые железом имеют важное значение на всех этапах жизни, их следует употреблять регулярно, особенно беременным женщинам, детям и пожилым людям, поскольку именно эти категории людей имеют наибольшую потребность в железе.

Таблица продуктов, богатых железом
Ниже приводится таблица с продуктами с высоким содержанием железа, животного и растительного источника:
| Продукт | Содержание железа, мг/100 г продукта |
|---|---|
| Какао-порошок | 14,8 |
| Печень свиная | 12,6 |
| Печень говяжья | 6,9 |
| Горох | 6,8 |
| Крупа гречневая | 6,7 |
| Фасоль | 5,9 |
| Почки говяжьи | 5,9 |
| Шоколад молочный | 5,0 |
| Сердце говяжье | 4,7 |
| Сердце свиное | 4,0 |
| Язык говяжий | 4,0 |
| Крупа овсяная | 3,9 |
| Хлеб ржаной | 3,9 |
| Дрожжи | 3,2 |
| Курага | 3,2 |
| Изюм | 3,0 |
| Чернослив | 3,0 |
| Фундук | 3,0 |
| Говядина | 2,9 |
| Яйцо куриное | 2,5 |
| Орехи грецкие | 2,3 |
| Яблоки | 2,2 |
| Свинина | 1,9 |
| Печень трески | 1,9 |

Суточная потребность организма в железе
Суточная потребность железа, как это можно видеть в таблице варьируется в зависимости от возраста и пола, а женщины имеют большую потребность в железе, чем мужчины, особенно во время беременности и кормления грудным молоком.
| Возраст | Мужчин | Женщин | Беременных | Кормящих |
|---|---|---|---|---|
| 0-6 мес. | 0.27 мг | 0.27 мг | ||
| 7–12 мес. | 11 мг | 11 мг | ||
| 1–3 года | 7 мг | 7 мг | ||
| 4–8 лет | 10 мг | 10 мг | ||
| 9–13 лет | 8 мг | 8 мг | ||
| 14–18 лет | 11 мг | 15 мг | 27 мг | 10 мг |
| 19–50 лет | 8 мг | 18 мг | 27 мг | 9 мг |
| 51+ год | 8 мг | 8 мг |
Симптомы избытка железа
Симптомы избытка железа в крови, такие как усталость, слабость и боль в животе трудно заметить, особенно у детей раннего возраста, потому что их часто путают с другими распространенными заболеваниями, такими как кишечные инфекции, например.
В общем, избыток железа приводит к изменению цвета кожи, которая становиться серо-голубых оттенков или металла, и, как правило, вызвано гемохроматозом, генетическое заболевание, при котором всасывание железа в кишечнике увеличивается.
Основными симптомами избытка железа в крови являются:
- утомляемость;
- слабость;
- импотенция;
- боли в животе;
- потеря веса;
- боль в суставах;
- выпадение волос;
- изменения менструального цикла;
- нарушения сердечного ритма;
- отеки.
Помимо гемохроматоза, высокие уровни железа в крови могут быть вызваны частым переливанием крови или чрезмерном потреблением добавок железа.
Железо, которое находится в избытке в организме может накапливаться в таких органах, как сердце, печени и поджелудочной железы, что может привести к осложнениям в виде увеличение количества жира в печени, циррозу печени, раку, учащенному сердцебиению, диабету и артриту. Кроме того, эта проблема также может вызвать преждевременное старение вследствие накопления свободных радикалов в клетках.
Как улучшить усвоение железа для борьбы с анемией?
Для улучшения всасывания железа в кишечнике рекомендуется потреблять цитрусовые фрукты (например апельсины или грейпфруты), ананасы, вишню, наряду с пищей богатой железом, приведенной в таблице 1, помимо этого избегать частого использования антацидных лекарственных препаратов, таких как омепразол.
Усвояемость железа улучшается, когда он находится в форме «гема», которая присутствует в продуктах животного происхождения, таких как мясо, печень и яичный желток. Некоторые пищевые продукты, такие как тофу, бобовые ростки также содержат железо, но этот тип не является железом гема и поглощается в кишечнике в незначительных количествах.
Советы по увеличению всасывания железа в ЖКТ:
- Избегайте употребления продуктов, богатых кальцием с основными приемами пищи, таких как йогурт, пудинг, молоко или сыр, потому что кальций является естественным ингибитором абсорбции железа;
- Избегайте употребления продуктов, содержащих много клетчатки, которая снижает эффективность поглощения железа;
- Избегайте чрезмерного употребления сладостей, красного вина, шоколада и некоторых трав, потому что они содержат полифенолы и фитаты, которые являются ингибиторы абсорбции железа;
- Ешьте фрукты, богатые витамином С, такие как апельсин, киви вместе с железосодержащими продуктами;
- Избегайте потребления молочных продуктов вместе основными приемами пищи, так как кальций уменьшает всасывание железа;
- Избегайте потребления кофе и чая, так как они содержат вещества, называемые полифенолы, которые уменьшают всасывание железа;
- Избегайте постоянного использования препаратов для лечения изжоги, потому что железо лучше усваивается с повышенной кислотности желудка;
- Ешьте продукты, богатые фруктоолигосахаридами, такие как соевые бобы, артишоки, спаржа, цикорий, чеснок и бананы.
Препараты для повышения гемоглобина и борьбы с анемией
Рекомендуемая дозировка железосодержащих добавок/препаратов и продолжительность лечения варьирует в зависимости от возраста пациента и степени тяжести анемии. Лечение проводится только длительным приёмом препаратов трёхвалентного железа. Стоит отдельно отметить, что существенный прирост гемоглобина, в отличие от улучшения самочувствия, будет не скорым не ранее чем через месяц-полтора
- Актиферрин,
- Гемофер,
- Сорбифер Дурулес,
- Тотема,
- Тардиферон,
- Фенюльс,
- Ферроплекс.

Длительность лечения анемии
Для лечения железодефицитной анемии требуется по крайней мере 3 месяца приема препаратов железа, пока запасы железа в организме не будут восстановлены. Таким образом, через 3 мес. после начала лечения рекомендуется сделать анализ крови на уровень железа.
Препараты для борьбы с анемией кроме железа могут содержать фолиевую кислоту и витамин В12, которые также помогают в борьбе с анемией.
Как правило, неправильное использование добавок железа вызывает такие проблемы, как изжога, тошнота и запоры, которые могут быть смягчены с помощью коррекции дозировки.
Виды железосодержащих препаратов
Пероральные железосодержащие препараты продаются в жидкой форме, и как правило, предназначенных для детей. Наиболее известной добавкой является сульфат железа, который следует принимать натощак и часто вызывает побочные эффекты, такие как тошнота и изжога, но есть и другие виды, которые вызывают меньше побочных эффектов.
В некоторых случаях железосодержащие препараты пациентам вводятся внутримышечно или внутривенно, то есть парентерально.
Побочные эффекты препаратов железа:
- Изжога и жжение в желудке;
- Тошнота и рвота;
- Металлический привкус во рту;
- Полное ощущение желудка;
- Диарея или запор.
Тошнота и дискомфорт в желудке увеличивается в зависимости от дозы препарата и обычно происходит от 30 до 60 минут после приема добавки, но может исчезнуть после первых 3 дней лечения. В любом случае, проводить курс лечения дефицита железа в организме необходимо под контролем врача, ведь железодефицитная анемия довольно опасный недуг и может вызывать осложнения.



Кто страдает дефицитом железа в организме человека, желательно не надо пить кофе, так оно усиливает снижения уровня железа.